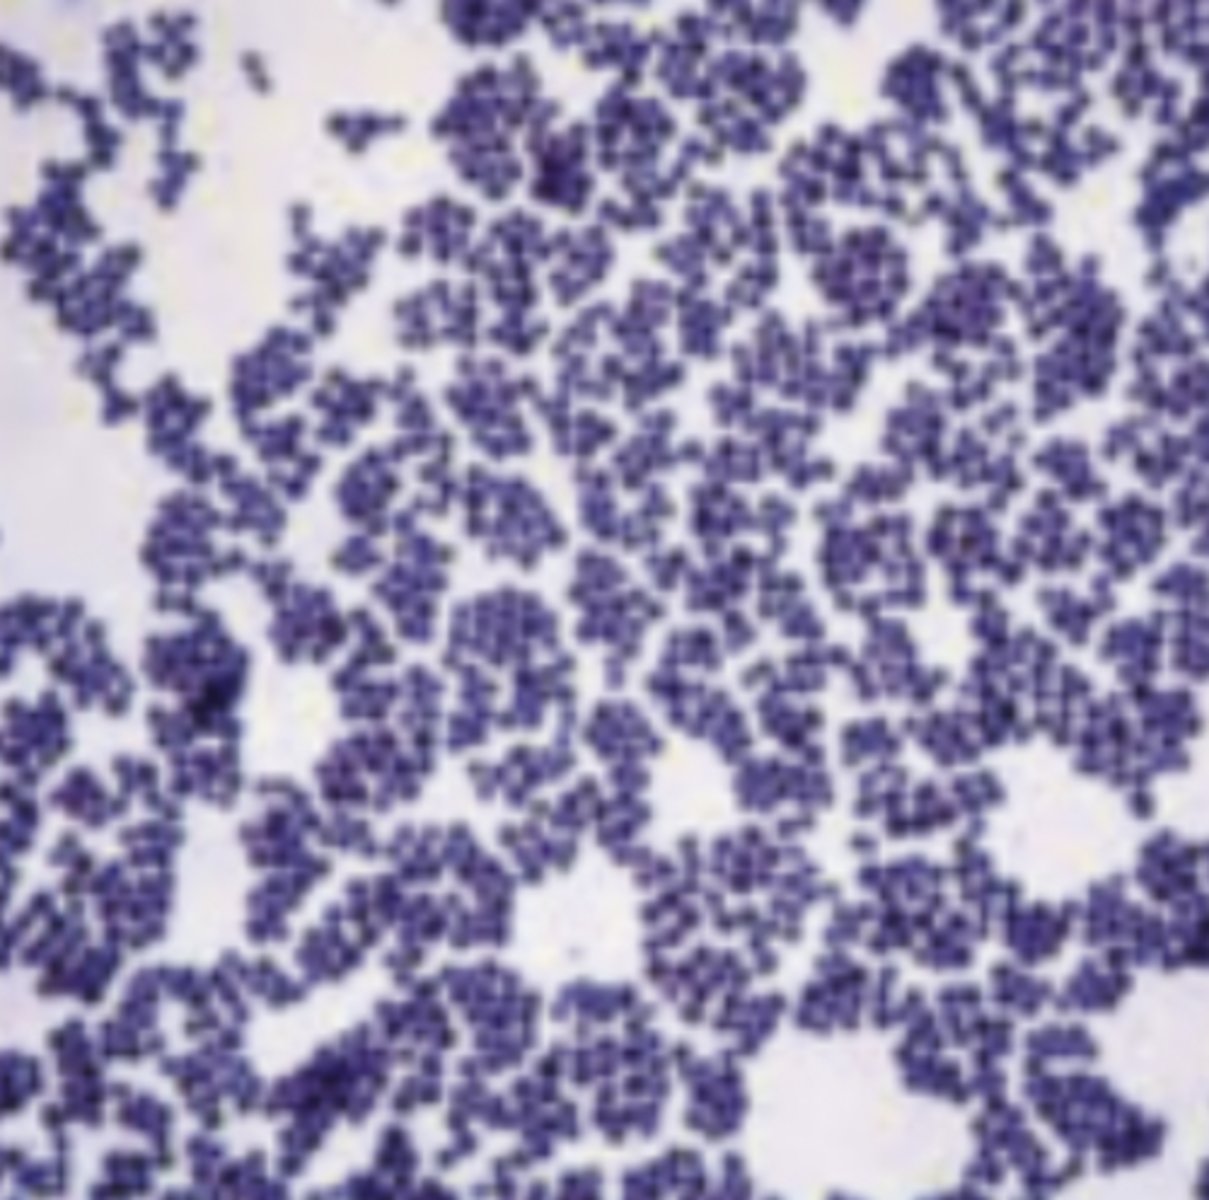
<p>Interpret the following gram stain reaction and describe the morphology</p>

1/285
Looks like no tags are added yet.
Name | Mastery | Learn | Test | Matching | Spaced | Call with Kai |
|---|
No analytics yet
Send a link to your students to track their progress

1
occulars/eye pieces

2
body tube

3
nose piece

4
condensor lens

5
objective lenses

6
coarse knob

7
fine knob

8
stage

9
illuminator

10
iris diaphragm
function of occulars/eye piece
what you view through
function of body tube
houses the lens system that magnifies the specimens
functions of nose piece
revolves and contains the objectives
function of condensor lens
two lens system gets light from the illuminator and lets through iris diaphragm
function of objective lens
magnifies the specimen
function of coarse knob
moves stage up and down
function of fine knob
helps make fine tuned adjustments to see plate clearly
function of stage
holds the slide with a hole in the center to let light from the illuminator in
the stage often contains ___ ___ to hold the slide in place
stage clips
function of illuminator
the light source at the base microscope
function of iris diaphragm (below stage)
controls amount of light let in by the illuminator
what is the total magnification for the following objective lens: 4X
40x
what is the total magnification for the following objective lens: 10X
100x
what is the total magnification for the following objective lens: 40X
400x
what is the total magnification for the following objective lens: 100X
1000X
Which focus knob(s) should you use with the 4x objective?
coarse and fine
Which focus knob(s) should you use with the 10x objective?
fine
Which focus knob(s) should you use with the 40x objective?
fine
Which focus knob(s) should you use with the 100x objective?
fine (and immersion oil)
If you are unable to focus at the 40x, what should you do? Should you just skip ahead to the 100x?
no, go back to previous objective and focus
What do you need to add when transitioning from the 40x to 100x objective lens?
immersion oil
What steps can you take to troubleshoot a blurry image?
Clean lens, adjust diaphram, go back to previous objective
definition of parfocal nature of the microscope
when you change the objective lens it will stay almost in focus
Describe how to use the par-focal nature of your microscope when observing a sample?
switching to next objective lens you will only have to use the fine knob
definition of parcentral feature of microscope
specimen stays centered when switching magnifications
What is the purpose of adding oil when using the 100x objective lens?
Improves resolution of the image and reduces light refraction
How do you properly carry a microscope?
both hands one on base one on handle
What kind of paper do you use to clean oil off a microscope lens?
lens paper
When looking at your wet mount under the microscope what did you notice about the difference in size between the bacterial cells and the cheek cells? Which one was bigger? Blood cells vs bacterial cells?
cheek cells, blood cells, bacteria

identify the shape of each cell
cocci

identify the shape of each cell
bacillus

Add multiple choice options
diplococci

coccus

diplococci

clusters

pairs (diplobacillus)

rods (bacilli)

chains (of cocci)

tetrads (of cocci)
What tool should be used to inoculate a plate? What about an agar deep?
loop, needle
You are transferring a sample from the stock tube to 3 different plates. Should you incinerate your loop between each inoculation?
yes
Describe the steps you would take to ensure aseptic conditions when transferring microorganisms from one culture to another.
Incinerate loop, close lid, hold at 45 degree
What are ways contamination could occur when culturing an agar plate?
Leaving lid open, not incinerating loop
Which micropipette would you use to transfer 12 μL?
P20
Which micropipette would you use to transfer 198 μL?
P200
Which micropipette would you use to transfer 300 μL?
P1000
What four things are needed when labeling a sample?
name, date, section, culture name
How should your plates be stored? Should the agar be on the bottom or top?
upside down agar on top
What part of the microscope would need to be adjusted to increase or decrease the contrast during a wet mount? Where on the microscope is this part located?
iris diaphragm, under stage
less light from iris diagraph = ___ (more/less) contract
more
more light from iris diagraph = ___ (more/less) contract
less
Why would a coverslip be used to observe bacteria?
Stops bacteria from moving, prevents lens from contamination
Order the following organisms from largest to smallest: E. coli, S. cerevisiae, cheek cell
cheek cell, S. cerevisiae, E. coli
What are the advantages of using a wet mount?
see living organisms, movement, simple to prepare
What are the disadvantages of using a wet mount?
hard to see details, can dry out, bacteria can move
What is a pure culture?
a culture with only one type of bacteria
What would the result be if you were culturing an agar plate and forgot to let the inoculating loop cool between sections 2 and 3?
kill the bacteria, no growth on sections 2 and3
Based on what characteristics can one ensure they have obtained a pure culture on their plate?
colonies have same, shape, color, texture, form

What is this method called?
T streak method
What could happen if you overheat the slide during the heat-fixing process?
it can kill the bacteria
What could happen if you underheat the slide during the heat-fixing process?
cells may wash off the slide
What happens if you heat-fix a slide before drying it?
can kill the bacteria
Why is it important to heat-fix the slide before applying stains?
so the bacteria stays on the slide during washing
How can an improperly prepared smear affect your gram stain results?
can give false positives or negatives
Process of making a smear from a solid culture
add drop of water and mix bacteria in
process of making a smear from a liquid culture
place on slide
What is the term for the liquid used to promote primary stain retention in a gram stain? What solution has this function in a gram stain?
iodine helps the primary stain stick better
name for primary stain
crystal violet
function of primary stain
stains all cells purple
name for mordant
iodine
function of mordant
fixes dye into cell wall
name for decolorization
95% ethanol
function of decolorizer
removes dye from gram negatives
name for counterstain
safarin
function of counterstain
stains gram negatives pink
Interpret the following gram stain reaction and describe the morphology
gram positive cocci in clusters

Interpret the following gram stain reaction and describe the morphology
gram negative bacilli (rods)
If your known gram negative rods appeared purple under the microscope. What mistake in the staining process would cause this?
crystal violet stain or ethanol
name two errors that can occur during the staining procedure and what they result in when looking at the slide through the microscope
too much or little colorizer and can cause incorrect color
What happens if you let the ethanol sit on the slide too long? Not long enough?
can strip purple dye, cause gram negatives to be purple
what happens if your sample is too thick on the smear
cells too clustered to identify
What equation was used to determine CFU/mL in the Quantitation lab?
number of colonies/total dilution
Using the same steps as in the Quantitation lab, if your plate had a total dilution of 10-7 had 57 colonies, what is the CFU/mL in the original sample?
5.7x10^8 CFU/mL
Calculate the CFU/mL of the original sample if you followed the same steps as in the quantitation lab for the following plate: Number of colonies = 268 and Plate = total dilution 10-5
2.68x10^7 CFU/mL

?
10^-6

?
10^-8
What is the difference between direct and indirect quantitation?
counting, measuring turbidity
How would results be affected by an uneven distribution of bacteria over plates during the direct method of quantification of microorganisms?
inaccurate doesn’t represent the true concentration
Although we did not plate the 10-1 tube in our Quantitation lab, based on your results, what would you expect your 10-2 plate to look like if you had?
TMC